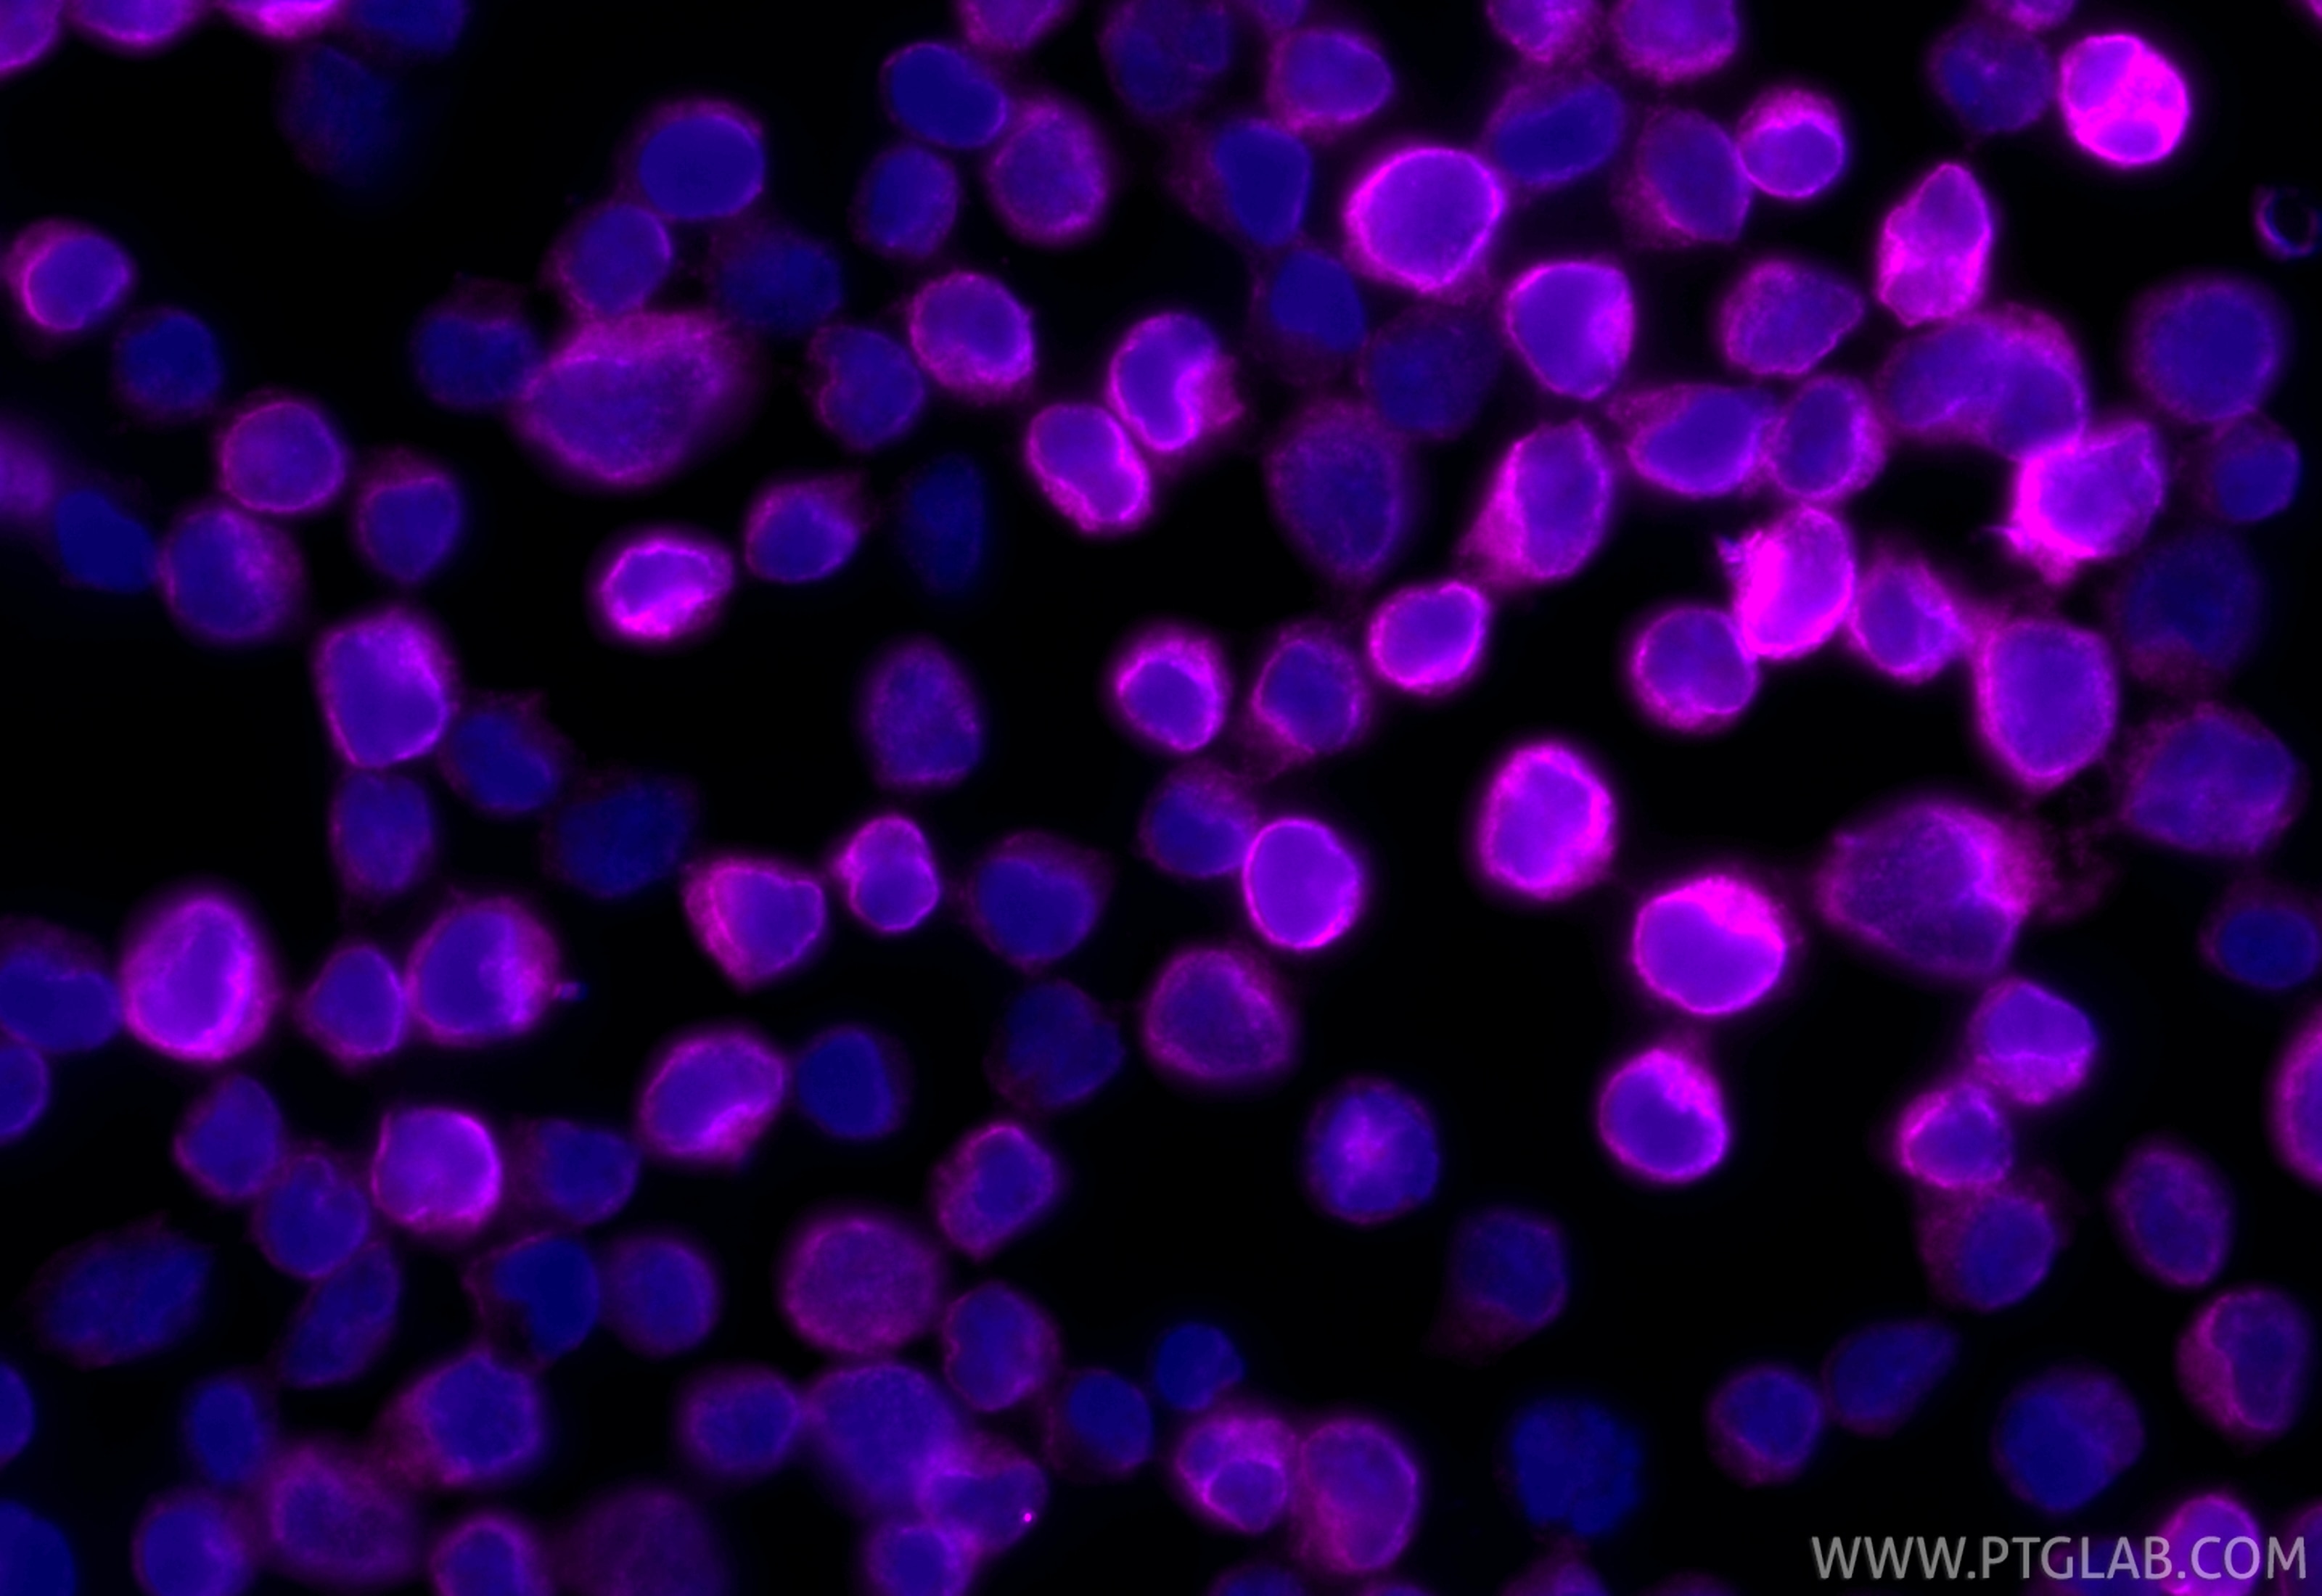
Immunofluorescence (IF) / fluorescent staining of Jurkat cells using CoraLite® Plus 647-conjugated CD3 Recombinant mono (CL647-84505-4)

Tested Applications
| Positive IF-P detected in | human tonsillitis tissue |
| Positive IF/ICC detected in | Jurkat cells |
Recommended dilution
| Application | Dilution |
|---|---|
| Immunofluorescence (IF)-P | IF-P : 1:50-1:500 |
| Immunofluorescence (IF)/ICC | IF/ICC : 1:50-1:500 |
| It is recommended that this reagent should be titrated in each testing system to obtain optimal results. | |
| Sample-dependent, Check data in validation data gallery. | |
Product Information
CL647-84505-4 targets CD3 in IF/ICC, IF-P applications and shows reactivity with human samples.
| Tested Reactivity | human |
| Host / Isotype | Rabbit / IgG |
| Class | Recombinant |
| Type | Antibody |
| Immunogen |
CatNo: Eg2144 Product name: Recombinant Human CD3 epsilon protein (rFc Tag) Source: mammalian cells-derived, pHZ-KIsec-C-rFc Tag: C-rFc Domain: 23-126 aa of BC049847 Sequence: DGNEEMGGITQTPYKVSISGTTVILTCPQYPGSEILWQHNDKNIGGDEDDKNIGSDEDHLSLKEFSELEQSGYYVCYPRGSKPEDANFYLYLRARVCENCMEMD Predict reactive species |
| Full Name | CD3e molecule, epsilon (CD3-TCR complex) |
| Calculated Molecular Weight | 207 aa, 23 kDa |
| Observed Molecular Weight | 23 kDa |
| GenBank Accession Number | BC049847 |
| Gene Symbol | CD3 |
| Gene ID (NCBI) | 916 |
| ENSEMBL Gene ID | ENSG00000198851 |
| Conjugate | CoraLite® Plus 647 Fluorescent Dye |
| Excitation/Emission Maxima Wavelengths | 654 nm / 674 nm |
| Excitation Laser | Red Laser (633 nm) |
| Form | Liquid |
| Purification Method | Protein A purification |
| UNIPROT ID | P07766 |
| Storage Buffer | PBS with 50% glycerol, 0.05% Proclin300, 0.5% BSA, pH 7.3. |
| Storage Conditions | Store at -20°C. Avoid exposure to light. Stable for one year after shipment. Aliquoting is unnecessary for -20oC storage. |
Background Information
CD3 is a complex of proteins that directly associates with the T cell receptor (TCR). The TCR/CD3 complex of T-lymphocytes consists of either a TCR alpha/beta or TCR gamma/delta heterodimer coexpressed at the cell surface with the invariant subunits of CD3 labeled gamma, delta, epsilon, zeta, and eta. The TCR recognizes antigens bound to major histocompatibility complex (MHC) molecules. TCR-mediated peptide-MHC recognition is transmitted to the CD3 complex, leading to the intracellular signal transduction. CD3 is considered to be a pan-T cell marker for detection of normal and neoplastic T cells. This antibody is directed against the epsilon chain of human CD3 molecule.
Protocols
| Product Specific Protocols | |
|---|---|
| IF protocol for CL Plus 647 CD3 antibody CL647-84505-4 | Download protocol |
| Standard Protocols | |
|---|---|
| Click here to view our Standard Protocols |